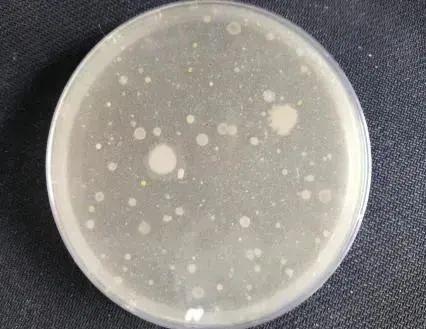

夏天吹空調,缺了這一步,真的容易吹出病



不想得
空調病
+++
這個動作很重要

先給空調洗個澡
氣溫攀升
又到空調使用季
*記得先給空調洗個澡*

隨着氣溫逐漸攀升
閒置很久的空調
又要“大展身手”啦
注意:
空調長時間未使用或室內空氣質量不良時,會積累大量灰塵,爲微生物生長提供條件,極大可能影響人類健康。
空調內部的微生物隨着空調的運行散播到室內空氣中,可能引起皮膚過敏、哮喘、肺炎等疾病,幾乎每年夏天都有因爲空調病進ICU的新聞。

微生物是怎樣對
健康造成危害的呢
實際上,空調中的微生物主要來自於室內空氣。如果我們沒有保持室內乾淨整潔,經常通風換氣以及定期清洗空調的習慣,那麼我們就很可能會因與致病菌親密接觸而患病。

空調的衛生狀況對
健康產生很大影響嗎
答案是肯定的
★ 由於致病菌污染空調,而導致人羣健康損害的事件已經遍及世界各國,並引起了各國政府的高度重視。
★ 對於集中空調通風系統我國已經有國家衛生標準和嚴格的衛生監督制度進行監管,以保障廣大羣衆的健康。
★ 而家用空調的衛生狀況則需要人們自身提高認識,定期維護保養,從而達到預防疾病的目的。

未及時清洗的
空調到底有多髒呢?
我們拿出了一個室內衛生條件還不錯的家中使用了1年的空調濾網,上面佈滿了灰塵和棉絮狀的物質,讓人感覺特別髒,很不舒服。

但是,這個世界上偏偏就有這麼一羣生物特別喜歡這樣的環境,它們就是肉眼看不到的微生物。一旦這些微生物佔領了空調濾網,便會抓緊時機在濾網上迅速繁殖,這也爲它們更好地進軍下一個陣地而做好準備。

當我們打開這樣一個沒有清洗過的空調時,大量的微生物被吹到室內空氣中,一個健康的人吸入大量的致病微生物後,便可能被擊倒了。
因此建議空調在長期不用重新開啓前一定要對其進行簡單清潔。

特別是對家中有體弱多病者或有過呼吸道傳染病病人的空調,更應加強清洗工作。
我們該如何清洗空調呢
01
斷電!斷電!斷電!
重要事情說三遍。
02
然後打開空調面板,取出空調過濾網。
03
清洗過濾網,可用空調專用清洗劑清洗處理污垢然後清水洗淨,需自然晾乾。

04
用半乾的抹布擦拭空調內部面板。

05
先將面板進行關閉復位後,再擦拭空調面板即可。


經試驗證實用清水直接沖洗空調濾網,濾網上的細菌總數能大大減少,而浸泡了消毒液的空調濾網,可以達到檢測不到細菌的程度,這說明浸泡消毒液的清洗效果更好。

*
讓我們來看下實驗結果!
清洗前

清水清洗1分鐘
浸泡30分鐘消毒液再清水清洗

好了,在瞭解了家用空調清洗的必要性及清洗步驟後,在炎熱的天氣來臨前,小夥伴們趕緊行動起來,幫家裏的空調洗洗澡吧!
小貼士:
適當開窗通風
★開空調時適當開窗通風,提高房間換氣次數,避免長時間封閉。

車輛保養
★車載空調的清潔也不能少。車輛保養時,別忘了檢查空調系統、冷凝器,及時更換空調濾芯。


總之
無論是中央空調系統、
分體式家用空調
還是車載空調
都是需要定期
清洗和維護的
來源:北京市疾病預防控制中心微信公衆號
編輯:郭蕾
審覈:潘華虹 畢天琦

















